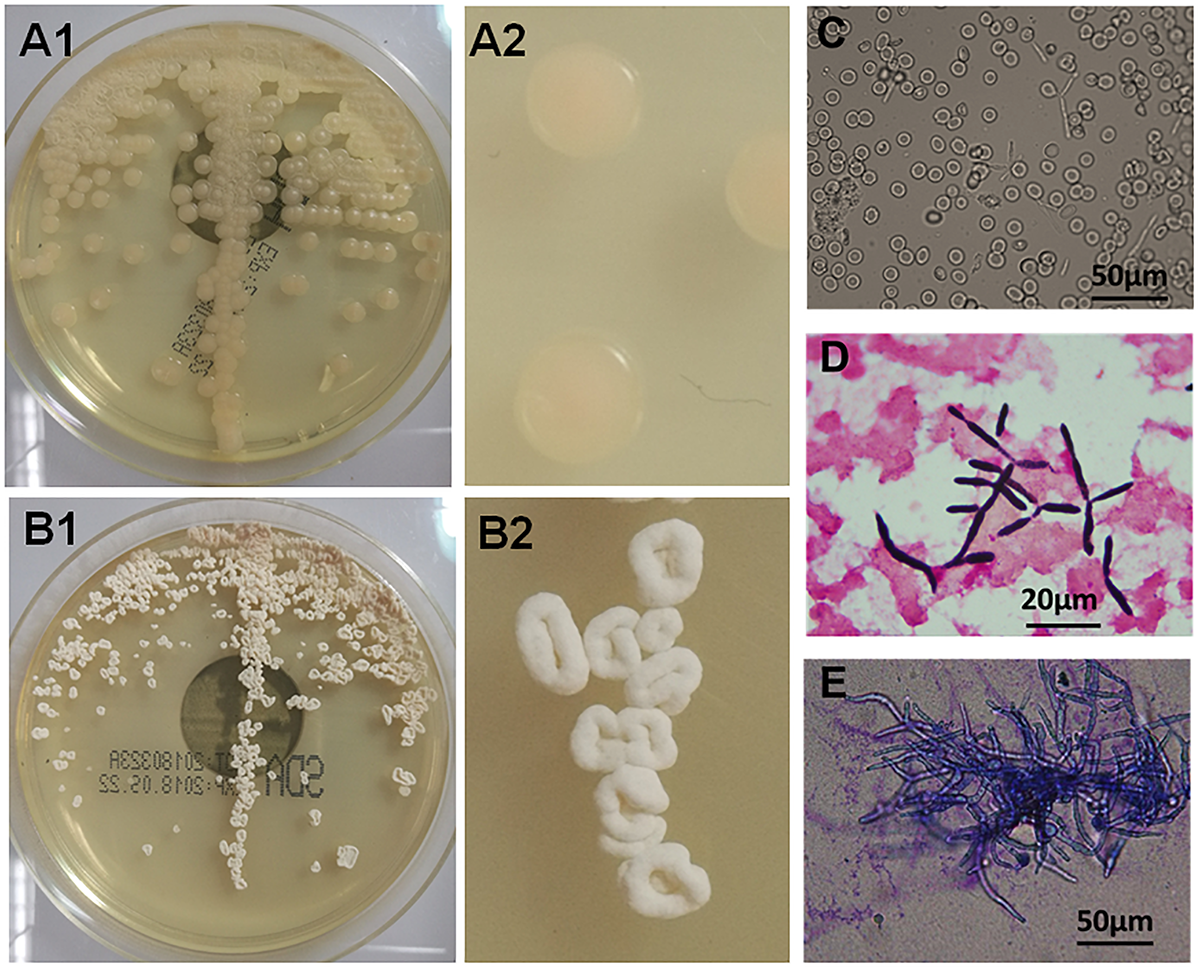
FIGURE 1

Abstract
Objective: To identify the pathogen causing fungemia in a Chinese patient and describe its morphological and molecular characterizes.
Methods: Samples of central and peripheral venous blood were collected for blood culture. Morphology and drug sensitivities of the isolated yeast-like fungus were analyzed. rDNA sequencing and molecular phylogenetic analysis of the isolated strains were performed using DNAMAN and MEGA software.
Results: A strain of yeast-like fungi was repeatedly isolated from blood samples of a Chinese patient. The isolates grew well on sabouraud medium broth plate. The colonies were smooth and round at 28°C, and were of rough surface and irregular shape at 35°C. Molecular phylogenetic trees constructed based on the internal transcribed spacer (ITS) and D1/D2 domains of 28S rDNA gene demonstrated the isolated yeast-like fungus was Moesziomyces antarcticus. Drug susceptibility test showed that this isolated M. antarcticus was resistant or had relatively low susceptibility to flucytosine, fluconazole, voriconazole, and itraconazole, and only sensitive to amphotericin.
Conclusion: This study provided more information for the molecular and morphology characteristics of M. antarcticus and reviewed the species information of Moesziomyces associated with human infections, which will contribute to the identification and diagnosis of Moesziomyces infections.
Introduction
The basidiomycetous yeast Moesziomyces antarcticus (previously cited as Pseudozyma antarctica), is originally isolated from a sediment sample obtained from Lake Vanda in Antarctica (Sugiyama et al., 1967), and belongs to the order Ustilaginales (Ustilaginomycetes and Ustilaginomycotina). Moesziomyces spp. is mainly isolated from plant surfaces and provides a natural source of protection against powdery mildews. Several Moesziomyces species have been reported to exhibit biological activity against biodegradable plastics, which are usually used in a number of industrial processes (Kitamoto et al., 2018). In recent years, more and more human cases infected by plant fungus have been reported. A total of 16 human cases caused by 10 kinds of Moesziomyces or Pseudozyma species had been reported in United States, China, Thailand, Brazil, India, France, Argentina, Korea and Nigeria from 2003 to 2015 (Table 1). Most of the cases were shown as fungaemia. Two dead cases were reported. One is a 78-year-old male patient diagnosed with astrocytoma in Korea, and a Pseudozyma species was isolated from the brain abscess (Hwang et al., 2010). Another dead case is a preterm low-birth-weight infant in Nigeria, and a strain of M. bullatus was isolated form her blood sample (Ojogba et al., 2015).
Table 1
| No. | strains | Age/sex | Underlying condition | Clinical presentation | |||||||
|---|---|---|---|---|---|---|---|---|---|---|---|
| 1 | M. antarcticus | N/A | N/A | N/A | |||||||
| 2 | M. antarcticus | 93/M | Hypertension, chronic renal insufficiency, Alzheimer’s disease, cerebral infarction | COPD | |||||||
| 3 | M. parantarctica | N/A | N/A | N/A | |||||||
| 4 | P. thailandica | N/A | N/A | N/A | |||||||
| 5 | M. aphidis | 7/F | Short gut syndrome | Fever, chill, malaise, and fatigue | |||||||
| 6 | M. aphidis | 51/M | Farmer, chronic leg swelling | Chronic mycetoma of leg | |||||||
| 7 | M. aphidis | 17/M | Burkitt lymphoma, chemotherapy | Neutropenic fever, lung infiltrates | |||||||
| 8 | M. aphidis | 0/M | Hemolytic jaundice | Lethargy, poor feeding | |||||||
| 9 | M. aphidis | 68/F | Adenocarcinoma of ampulla of Vater | Fever, chill | |||||||
| 10 | M. aphidis | 6/F | Osteosarcoma with lung metastasis | Neutropenic fever | |||||||
| 11 | M. aphidis | 51/M | AML, reinduction chemotherapy | Neutropenic fever, lung infiltrates | |||||||
| 12 | P. alboarmeniaca | N/A | N/A | N/A | |||||||
| 13 | P. crassa | N/A | N/A | N/A | |||||||
| 14 | P. siamensis | N/A | N/A | N/A | |||||||
| 15 | Pseudozyma spp. | 78/M | Astrocytoma | Fever after brain surgery | |||||||
| 16 | Pseudozyma spp. | 52/F | Crohn’s disease, total colectomy state | Fever, headache, and weakness | |||||||
| 17 | M. bullatus | 0/F | preterm low birth weight | Low body temperature, jaundice, bilateral pitting pedal oedema | |||||||
| No. | Isolated specimen | MIC | Treatment | Country, year (reference) | |||||||
| FLC | ITC | VRC | AMB | CAS | 5FC | ||||||
| 1 | Blood | 0.5 | 0.06 | N/A | 0.12 | N/A | >64 | N/A | Thai, 2003 (Sugita et al., 2003) | ||
| 2 | Blood | 128 | 4 | 8 | <0.5 | N/A | >16 | CAS→LAMB | China, 2018 (This case) | ||
| 3 | Blood | 2 | 0.25 | N/A | 0.25 | N/A | >64 | N/A | Thai, 2003 (Sugita et al., 2003) | ||
| 4 | Blood | >64 | >8 | N/A | 0.25 | N/A | >64 | N/A | Thai, 2003 (Sugita et al., 2003) | ||
| 5 | Blood | 4 | 0.12 | N/A | 0.25 | N/A | N/A | FLC→ITC | United States, 2007 (Lin et al., 2008) | ||
| 6 | Leg | N/A | N/A | N/A | N/A | N/A | N/A | ITC | China, 2011 (Chen et al., 2011) | ||
| 7 | Pleural fluid | 4 | 0.25 | 0.03 | 0.25 | 4 | N/A | LAMB→VRC | Brazil, 2012 (Parahym et al., 2013) | ||
| 8 | Blood | 8 | 0.03 | 0.06 | 0.03 | 8 | >64 | AMB→VRC | India, 2013 (Prakash et al., 2014) | ||
| 9 | Blood | 16 | 0.19 | 0.03 | 0.19 | >32 | >32 | LAMB | France, 2015 (Herb et al., 2015) | ||
| 10 | Blood | 2 | 0.03 | 0.03 | 0.13 | N/A | 128 | LAMB | Argentina, 2013 (Orecchini et al., 2015) | ||
| 11 | Blood | N/A | N/A | N/A | N/A | N/A | N/A | LAMB→VRC | Korea 2015 (Joo et al., 2016) | ||
| 12 | Blood | 32 | 4 | 2 | 0.25 | >16 | >64 | N/A | Thai, 2014 (Mekha et al., 2014) | ||
| 13 | Blood | >64 | 4 | 2 | 0.25 | >16 | >64 | N/A | Thai, 2014 (Mekha et al., 2014) | ||
| 14 | Blood | 32 | 4 | 2 | 0.12 | >16 | >64 | N/A | Thai, 2014 (Mekha et al., 2014) | ||
| 15 | Abscess of brain | N/A | N/A | N/A | N/A | N/A | N/A | N/A | Korea, 2009 (Hwang et al., 2010) | ||
| 16 | Blood | N/A | N/A | N/A | N/A | N/A | N/A | FLC→VRC | United States, 2014 (Siddiqui et al., 2014) | ||
| 17 | Blood | 128 | 0.12 | 0.03 | 1 | 8 | 64 | FLC | Nigeria, 2014 (Ojogba et al., 2015) | ||
Cases and strains information of Moesziomyces or Pseudozyma species infections in human.
FLC, fluconazole; ITC, itraconazole; VRC, voriconazole; AMB, amphotericin B; CAS, caspofungin; 5FC, flucytosine; LAMB, liposomal amphotericin B; N/A, not available.
Only one case was infected with M. antarcticus (Pseudozyma Antarctica used in the report) in 2003, Thailand, while case information were not shown in this report (Sugita et al., 2003). In this study, we isolated a strain of M. antarcticus from the blood of a Chinese patient, which is the second reported case infected by M. antarcticus to date in the world. Here we present the isolation and morphology of the yeast-like genus M. antarcticus.
Materials and Methods
Sequence Analysis
In Feb and Mar 2018, a strain of yeast-like fungus (sample No. 1801245875) was isolated from blood samples of a patient in General Hospital of Chengdu Military Region. Nuclear DNA from these isolates was extracted. The D1/D2 regions of 28S rDNA (also as ribosomal large subunit, LSU), the ribosomal small subunit (SSU) sequence of 18S rDNA and the internal transcribed spacer (ITS) regions of the rRNA gene were sequenced directly from PCR products using the primers 5.8SR/LR7, SR1R/SR6, and ITS-1/ITS-4, respectively (Guzmán-Dávalos et al., 2017). This strain has been deposited in China Centre for Type Culture Collection (CCTCC)1.
The nucleotide sequences determined in this study have been deposited with GenBank and the accession numbers were MH185803 for ITS, MH185804 for LSU and MH185805 for SSU. Alignment of sequences was performed using DNAMAN software (Lynnon Biosoft). Phylogenetic trees were constructed using MEGA version 6.06 by neighbor-joining method with 1000 bootstrap replicates.
Morphological and Physiological Characteristics
The isolated fungus was inoculated on Shalegar medium and cultured at 28 and 35°C. The colony growth was observed each day. The morphological characteristics were examined using a DM2000 microscope system (Leica, Germany).
In vitro Susceptibility Test
The MIC of 5-flucytosine (5-FC), fluconazole, voriconazole, amphotericin B, and itraconazole was determined using the ATB FUNGUS 3 (bioMérieux, La Balme-les Grottes, France) in accordance with the manufacturer’s instructions. The microplates were incubated at 35°C for 48 and 72 h.
Results
The patient is a 93-year-old male patient, who had chronic obstructive pulmonary disease (COPD) carrying a tracheal intubation after tracheostomy more than 1 year ago. In addition the patient was underlying causes of hypertension, chronic renal insufficiency, Alzheimer’s disease, cerebral infarction. On hospital day 9, fever developed as high as 38.5°C. Central and peripheral venous blood samples were collected for microbial examination and blood culture test, which showed a yeast-like fungus after cultured 12 to 24 h. Drug susceptibility test showed that the isolated fungus was resistant or had relatively low susceptibility to flucytosine, fluconazole, voriconazole and itraconazole, and only sensitive to amphotericin (Supplementary Table S2). Considering the nephrotoxicity of liposomal amphotericin B (LAMB), the patient was then treated with caspofungin. Central and peripheral venous blood samples were collected for culture at 3 and 6 days after caspofungin treatment. Fungemia was not under control, and caspofungin was changed to LAMB. After 2 weeks of treatment, the results of blood culture tests were all fungus negative.
The yeast-like fungus grew well on sabouraud medium broth, and had a different colony features cultured at different temperature. The colonies were smooth and round when cultured at 28°C (Figure 1A1,A2), and were of rough surface and irregular shape cultured at 35°C (Figure 1B1,B2). The isolated strains had a yeast-like form culture in the blood culture flasks (Figure 1C) and synnema-like structure (Figure 1D) on sabouraud medium, and could also form long tubular septate hyphae (Figure 1E). The fungus exhibited as lavender colored yeast-like colonies on the chromogenic agar medium of CHROMagar (Supplementary Figure S1). It is difficult to identify the species of the pathogen from the morphological and physiological characterizes. For molecular identification, the ITS sequence of isolated fungus showed 100% identity to P. antarctica (GenBank accession No. AB089358), and had one site of mutation of C-A compared with P. antarctica strains (GenBank accession Nos. AF294698, JN942669, and JX094775). Molecular phylogenetic trees constructed based on ITS and D1D2 demonstrated the isolated yeast-like fungus exhibited the highest sequence similarity with P. antarctica (Supplementary Figures S2, S3). As mentioned above and in discussion section, P. antarctica was now renamed to M. antarcticus.
FIGURE 1
Morphological and physiological characteristics of isolated Moesziomyces antarcticus. (A1,A2) Smooth colonies of M. antarcticus after 2 days growth on sabouraud medium at 28°C. (B1,B2) Colony morphology of M. antarcticus after 2 days growth on sabouraud medium at 35°C. Direct microscopic examination (C) and gram staining (D) of fungi in blood culture flasks. (E) The hyphae cells were examined with methylene blue staining after growing in sabouraud medium broth at 35°C for 4 days.
Moesziomyces infected case in China is rare. There has been only one reported human infection caused by M. aphidis in mycetoma on the leg, while this isolation is not available for us. Several related Moesziomyces species were obtained from China General Microbiological Culture Collection Center (Supplementary Table S1). All the tested Moesziomyces species had similar spore and mycelium characterizes. It was interesting to note that only M. antarcticus exhibit biphasic growth characteristics at 28 and 35 degree. Morphology characterizes of colonies of M. tsukubaensis, M. hubeiensis, M. aphidis, and M. rugulosus were extremely similar growth at 28 and 35 degree (Supplementary Figure S1). Drug susceptibility test showed that M. antarcticus and M. rugulosus were only sensitive to AMB, while M. tsukubaensis, M. hubeiensis and M. aphidis were sensitive to AMB, VRC, and ITC (Supplementary Table S2).
Discussion
Taxonomy of fungi has always been a tricky puzzle to microbiologist. M. antarcticus was initially described as Sporobolomyces antarcticus isolated from the 9-m deep sediment of Lake Vanda in Antarctica (Goto et al., 1969), which was transferred to the genera Candida in 1983 (Barnett et al., 1983) and Vanrija in 1987 (Moore, 1987). Then the species was combined with the genus Pseudozyma and described as Pseudozyma antarctica in 1995 (Boekhout, 1995). Recently, P. antarctica was transferred to the genus Moesziomyces in 2015 and now described as M. antarcticus (Wang et al., 2015; Kruse et al., 2017).
Moesziomyces infections in humans have been repeatedly reported since the first description as a human pathogen in 2003. Most of these cases were immunocompromised patients and carried out foreign materials, such as central venous catheter. In this study, we reported a strain of M. antarcticus isolated from the blood samples of a Chinese patient. The patient was ‘super senior’ elderly and had multiple chronic conditions who belonged to immunocompromised person. The case stayed in bed for a long period of time, and multiple catheters were placed into his body including a central vein catheter, an urinary catheter an airway catheter. The catheters may be one of the causes of fungal infection in this case.
A total of 10 species of Moesziomyces were reported in 17 human cases (Table 1), among which M. aphidis is most frequent (7/17). Over 80% (14/17) of these strains were isolated from blood samples, the other three were isolated form leg, pleural fluid and abscess of brain, respectively. Morphological characterizes of these isolates were similar between each other, which made it difficult to identify the species from morphology. Drug susceptibility of these isolates was quite different. M. antarcticus isolated by Sugita in Thailand, in 2003 was sensitive to fluconazole (FLC) and itraconazole (ITC), while our isolate in this case was resistant to FLC and ITC. The intensive use of antimicrobial drugs probably increased the microbial resistance.
It is worth to note that rare fungi have recently been implicated in human infections and have increased dramatically over recent decades especially in immunocompromised patients. This may be due to the continuous expansion of the field of human behaviors and the other due to the advances in diagnostic techniques. The risk factors included immunosuppression and foreign material, such as catheter. Molecular analysis of rDNA sequences is still an effective tool for fungi identification.
Statements
Ethics statement
This study was conducted according to the principles of the Declaration of Helsinki and approved by the ethics committee of General Hospital of Chengdu Military Region. This study aims to analysis the morphology and molecular analysis of the isolated pathogens and does not involve patients’ identification information. Therefore, the need for written informed consent was waived and oral informed consent was obtained.
Author contributions
YL and JX conceived and designed the experiments and wrote the paper. YL and ZZ carried out the DNA extraction and library preparation. ZH and WW contributed to sequencing and phylogenetic analysis. All authors read and approved the final manuscript.
Funding
This work was supported by China Postdoctoral Science Foundation (2017M623427, 2018T111157, 2017M613427, and 2017T100820), National Natural Science Foundation of China (81301445), and Applied Basic Research Project of Science and Technology Department in Sichuan (2013JY0173).
Conflict of interest
The authors declare that the research was conducted in the absence of any commercial or financial relationships that could be construed as a potential conflict of interest.
Supplementary material
The Supplementary Material for this article can be found online at: https://www.frontiersin.org/articles/10.3389/fmicb.2019.00254/full#supplementary-material
Footnotes
References
1
BarnettJ. A.PayneR. W.YarrowD. (1983). Yeasts: Characteristics and Identification.New York, NY: Cambridge University Press.
2
BoekhoutT. (1995). Pseudozyma Bandoni emend. Boekhout, a genus for yeast-like anamorphs of Ustilaginales.J. Gen. Appl. Microbiol.41359–366. 10.2323/jgam.41.359
3
ChenB.ZhuL. Y.XuanX.WuL. J.ZhouT. L.ZhangX. Q.et al (2011). Isolation of both Pseudozyma aphidis and Nocardia otitidiscaviarum from a mycetoma on the leg.Int. J. Dermatol.50714–719. 10.1111/j.1365-4632.2010.04814.x
4
GotoS.SugiyamaJ.IizukaH. (1969). A taxonomic study of Antarctic yeasts.Mycologia61748–774. 10.1080/00275514.1969.12018794
5
Guzmán-DávalosL.PradeepC. K.VrindaK. B.ManojK. A.RamÃrez-CruzV.HerreraM.et al (2017). A new stipitate species of Crepidotus from India and Thailand, with notes on other tropical species.Mycologia109804–814. 10.1080/00275514.2017.1401834
6
HerbA.SabouM.DelhormeJ. B.PessauxP.MutterD.CandolfiE.et al (2015). Pseudozyma aphidis fungemia after abdominal surgery: first adult case.Med. Mycol. Case Rep.837–39. 10.1016/j.mmcr.2015.03.001
7
HwangS.KimJ.YoonS.ChaY.KimM.YongD.et al (2010). First report of brain abscess associated with Pseudozyma species in a patient with astrocytoma.Korean J. Lab. Med.30284–288. 10.3343/kjlm.2010.30.3.284
8
JooH.ChoiY. G.ChoS. Y.ChoiJ. K.LeeD. G.KimH. J.et al (2016). Pseudozyma aphidis fungaemia with invasive fungal pneumonia in a patient with acute myeloid leukaemia: case report and literature review.Mycoses5956–61. 10.1111/myc.12435
9
KitamotoH.YoshidaS.KoitabashiM.Yamamoto-TamuraK.UedaH.YarimizuT.et al (2018). Enzymatic degradation of poly-butylene succinate-co-adipate film in rice husks by yeast Pseudozyma antarctica in indoor conditions.J. Biosci. Bioeng.125199–204. 10.1016/j.jbiosc.2017.08.017
10
KruseJ.DoehlemannG.KemenE.ThinesM. (2017). Asexual and sexual morphs of Moesziomyces revisited.IMA Fungus8117–129. 10.5598/imafungus.2017.08.01.09
11
LinS. S.PranikoffT.SmithS. F.BrandtM. E.GilbertK.PalavecinoE. L.et al (2008). Central venous catheter infection associated with Pseudozyma aphidis in a child with short gut syndrome.J. Med. Microbiol.57(Pt 4), 516–518. 10.1099/jmm.0.47563-0
12
MekhaN.TakashimaM.Boon-LongJ.ChoO.SugitaT. (2014). Three new basidiomycetous yeasts, Pseudozyma alboarmeniaca sp. nov., Pseudozyma crassa sp. nov. and Pseudozyma siamensis sp. nov. isolated from Thai patients.Microbiol. Immunol.589–14. 10.1111/1348-0421.12111
13
MooreR. T. (1987). Additions to the genus Vanrija.Bibl. Mycol.108167–173.
14
OjogbaM. O.AnneD.BoseT.NnaemekaE. N.MebiG. A.IkennaK. O.et al (2015). First report of neonatal sepsis due to Moesziomyces bullatus in a preterm low-birth-weight infant.JMM Case Rep.20151–4. 10.1099/jmmcr.0.000011
15
OrecchiniL. A.OlmosE.TavernaC. G.MurisengoO. A.SzuzsW.VivotW.et al (2015). First case of fungemia due to Pseudozyma aphidis in a pediatric patient with osteosarcoma in Latin America.J. Clin. Microbiol.533691–3694. 10.1128/JCM.01095-15
16
ParahymA. M.da SilvaC. M.Domingos IdeF.GonçalvesS. S.Rodrigues MdeM.de MoraisV. L.et al (2013). Pulmonary infection due to Pseudozyma aphidis in a patient with Burkitt lymphoma: first case report.Diagn. Microbiol. Infect Dis.75104–106. 10.1016/j.diagmicrobio.2012.09.010
17
PrakashA.WankhedeS.SinghP. K.AgarwalK.KathuriaS.SenguptaS.et al (2014). First neonatal case of fungaemia due to Pseudozyma aphidis and a global literature review.Mycoses5764–68. 10.1111/myc.12098
18
SiddiquiW.AhmedY.AlbrechtH.WeissmanS. (2014). Pseudozyma spp catheter-associated blood stream infection, an emerging pathogen and brief literature review.BMJ Case Rep.2014:bcr2014206369. 10.1136/bcr-2014-206369
19
SugitaT.TakashimaM.PoonwanN.MekhaN.MalaithaoK.ThungmuthasawatB.et al (2003). The first isolation of ustilaginomycetous anamorphic yeasts, Pseudozyma species, from patients’ blood and a description of two new species: P. parantarctica and P. thailandica.Microbiol. Immunol.47183–190. 10.1111/j.1348-0421.2003.tb03385.x
20
SugiyamaJ.SugiyamaY.IizukaH.ToriiT. (1967). Report of the Japanese summer parties in dry valleys, Victoria Land, 1963–1965. IV. Mycological studies of the Antarctic fungi. Part. 2. Mycoflora of Lake Vanda, an ice-free lake.Antarct. Rec.2823–32.
21
WangQ. M.BegerowD.GroenewaldM.LiuX. Z.TheelenB.BaiF. Y.et al (2015). Multigene phylogeny and taxonomic revision of yeasts and related fungi in the Ustilaginomycotina.Stud. Mycol.8155–83. 10.1016/j.simyco.2015.10.004
Summary
Keywords
Moesziomyces, taxonomy, Moesziomyces antarcticus, fungemia, morphology, internal transcribed spacer
Citation
Liu Y, Zou Z, Hu Z, Wang W and Xiong J (2019) Morphology and Molecular Analysis of Moesziomyces antarcticus Isolated From the Blood Samples of a Chinese Patient. Front. Microbiol. 10:254. doi: 10.3389/fmicb.2019.00254
Received
25 October 2018
Accepted
30 January 2019
Published
15 February 2019
Volume
10 - 2019
Edited by
Maurizio Sanguinetti, Catholic University of Sacred Heart, Italy
Reviewed by
Ana Alastruey-Izquierdo, Instituto de Salud Carlos III, Spain; Ferry Hagen, Westerdijk Fungal Biodiversity Institute, Netherlands
Updates
Copyright
© 2019 Liu, Zou, Hu, Wang and Xiong.
This is an open-access article distributed under the terms of the Creative Commons Attribution License (CC BY). The use, distribution or reproduction in other forums is permitted, provided the original author(s) and the copyright owner(s) are credited and that the original publication in this journal is cited, in accordance with accepted academic practice. No use, distribution or reproduction is permitted which does not comply with these terms.
*Correspondence: Yuan Liu, liuyuan198231@163.com Jie Xiong, xiongjie1969@126.com
This article was submitted to Fungi and Their Interactions, a section of the journal Frontiers in Microbiology
Disclaimer
All claims expressed in this article are solely those of the authors and do not necessarily represent those of their affiliated organizations, or those of the publisher, the editors and the reviewers. Any product that may be evaluated in this article or claim that may be made by its manufacturer is not guaranteed or endorsed by the publisher.